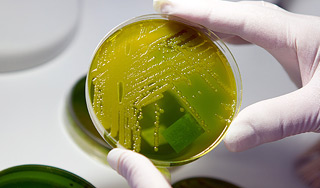
Бактерии избавят людей от лишнего веса Бактерии избавят людей от лишнего веса

10 октября, четверг | ![]() ![]() ![]() |
![]() | ПОЛИТИКА | ЭКОНОМИКА | ОБЩЕСТВО | ПРОИСШЕСТВИЯ | КУЛЬТУРА | СПОРТ | МЕДИА | В МИРЕ | АВТО | ТЕХНОЛОГИИ | ![]() |
| Фоторепортажи | Видеосюжеты | Комментарии | Погода | Работа | Форум | Карта | Подписка и RSS | Реклама| О газете |
Бактерии избавят людей от лишнего веса29 марта 2013, пятница, 00:44 – БРЯНСК.RU | Комментарии: 0
| Версия для печати Американские исследователи нашли новый способ борьбы с лишним весом. Ими был открыт безоперационный способ желудочного шунтирования – пересадки бактерий из здорового организма.Желудочное шунтирование – самая популярная в мире хирургическая операция, которую проводят даже чаще удаления аппендикса. Она направлена в первую очередь на снижение веса. Несмотря на широкую распространенность этой процедуры, риск летального исхода все же есть. Он особенно велик для очень полных людей. Команда исследователей из Центральной больницы Массачусетса разработала новый способ желудочного шунтирования, который не требует хирургического вмешательства. В ходе эксперимента ученые подмешивали в пищу лабораторным мышам кишечные бактерии от мышей, перенесших желудочное шунтирование. После двухнедельного приема такого бактериального коктейля животные потеряли около 5% собственного веса. Дело в том, что люди или животные, страдающие ожирением, имеют бактериальный состав кишечника, отличный от состава тех, у кого нормальный вес. Пересадка бактерий имеет множество физиологических последствий, таких как изменение гормонального фона, состава желчных кислот и даже деформацию нервных соединений. Пока остается загадкой, какие изменения происходят в организме после пересадки кишечных бактерий от другого животного. Но ученые надеются, что рано или поздно они изучат жизнедеятельность пересаженных бактерий и поймут принцип работы такого метода. Тогда медики смогут воссоздать производимый ими эффект в искусственной среде, чтобы полностью исключить необходимость хирургического вмешательства. Сейчас авторы исследования предполагают, что работа бактерий связана с их влиянием на всасывание питательных веществ или на скорость метаболизма. Суть операции желудочного шунтирования состоит в том, что желудок человека, страдающего излишним весом или ожирением, прошивается и разделяется на два отдела, главный из которых не превышает по объему 50 миллилитров. Из-за этого после операции человек наедается меньшим количеством пищи (параллельно уменьшается всасываемость питательных веществ). Добавим, что трансплантация кишечных бактерий уже имела место в медицинской практике. В 2010 году 89-летней женщине, страдавшей смертельным инфекционным заболеванием, сделали фекальную трансплантацию живых бактерий от ее собственного сына. Спустя всего сутки температура ее тела начала снижаться и болезнь вскоре отступила. Также подобная терапия помогла в лечении болезни Паркинсона, рассеянного склероза, ревматоидного артрита и синдрома хронической усталости. Источник:
|
![]() | ПОЛИТИКА | ЭКОНОМИКА | ОБЩЕСТВО | ПРОИСШЕСТВИЯ | КУЛЬТУРА | СПОРТ | МЕДИА | В МИРЕ | АВТО | ТЕХНОЛОГИИ | ![]() |
| Фоторепортажи | Видеосюжеты | Комментарии | Погода | Работа | Форум | Карта | Подписка и RSS | Реклама| О газете |
| Размещение рекламы в газете БРЯНСК.RU: Прайс-лист, тел. (4832) 37-19-38, почта info@briansk.ru Для информационных писем в редакцию: news@briansk.ru | ![]() | ![]() | ||
| 2005–2015 © Ежедневная интернет-газета БРЯНСК.RU При цитировании активная ссылка на БРЯНСК.RU обязательна Материалы газеты могут содержать информацию 18+ | ![]() | Открыв данный сайт, Вы соглашаетесь с Правилами cайта (договор-оферта). Если вы не согласны с Правилами, немедленно покиньте сайт! | ![]() |

Cryptorussia.ru: ваш путеводитель в мир трейдинга
Мир азартных игр: как выбрать надежную площадку?
Легкая одежда: комфорт, стиль и доступность
Игра удачи: Светлая и темная сторона азартных игр
SMS-реклама — эффективный инструмент для бизнеса
Король футбола подал в суд на Samsung
"Горячий юпитер" поразил ученых (видео)
Рождение детей обойдется без секса







ПОПУЛЯРНЫЕ МАТЕРИАЛЫ










